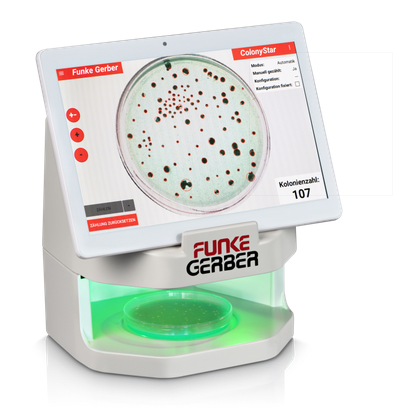

ColonyStar automatic 8550 Funke Gerber
Kategori: Alat Kesehatan, Alat Laboratorium, Semua Produk
Jadilah yang pertama memberikan ulasan “ColonyStar automatic 8550 Funke Gerber” Batalkan balasan
Produk Terkait
-
Sale

Fusce nec diam et dolor
Rp100Harga aslinya adalah: Rp100.Rp99Harga saat ini adalah: Rp99.Pilih opsi Produk ini memiliki beberapa varian. Pilihan ini dapat diambil di halaman produk -
-

Ulasan
Belum ada ulasan.